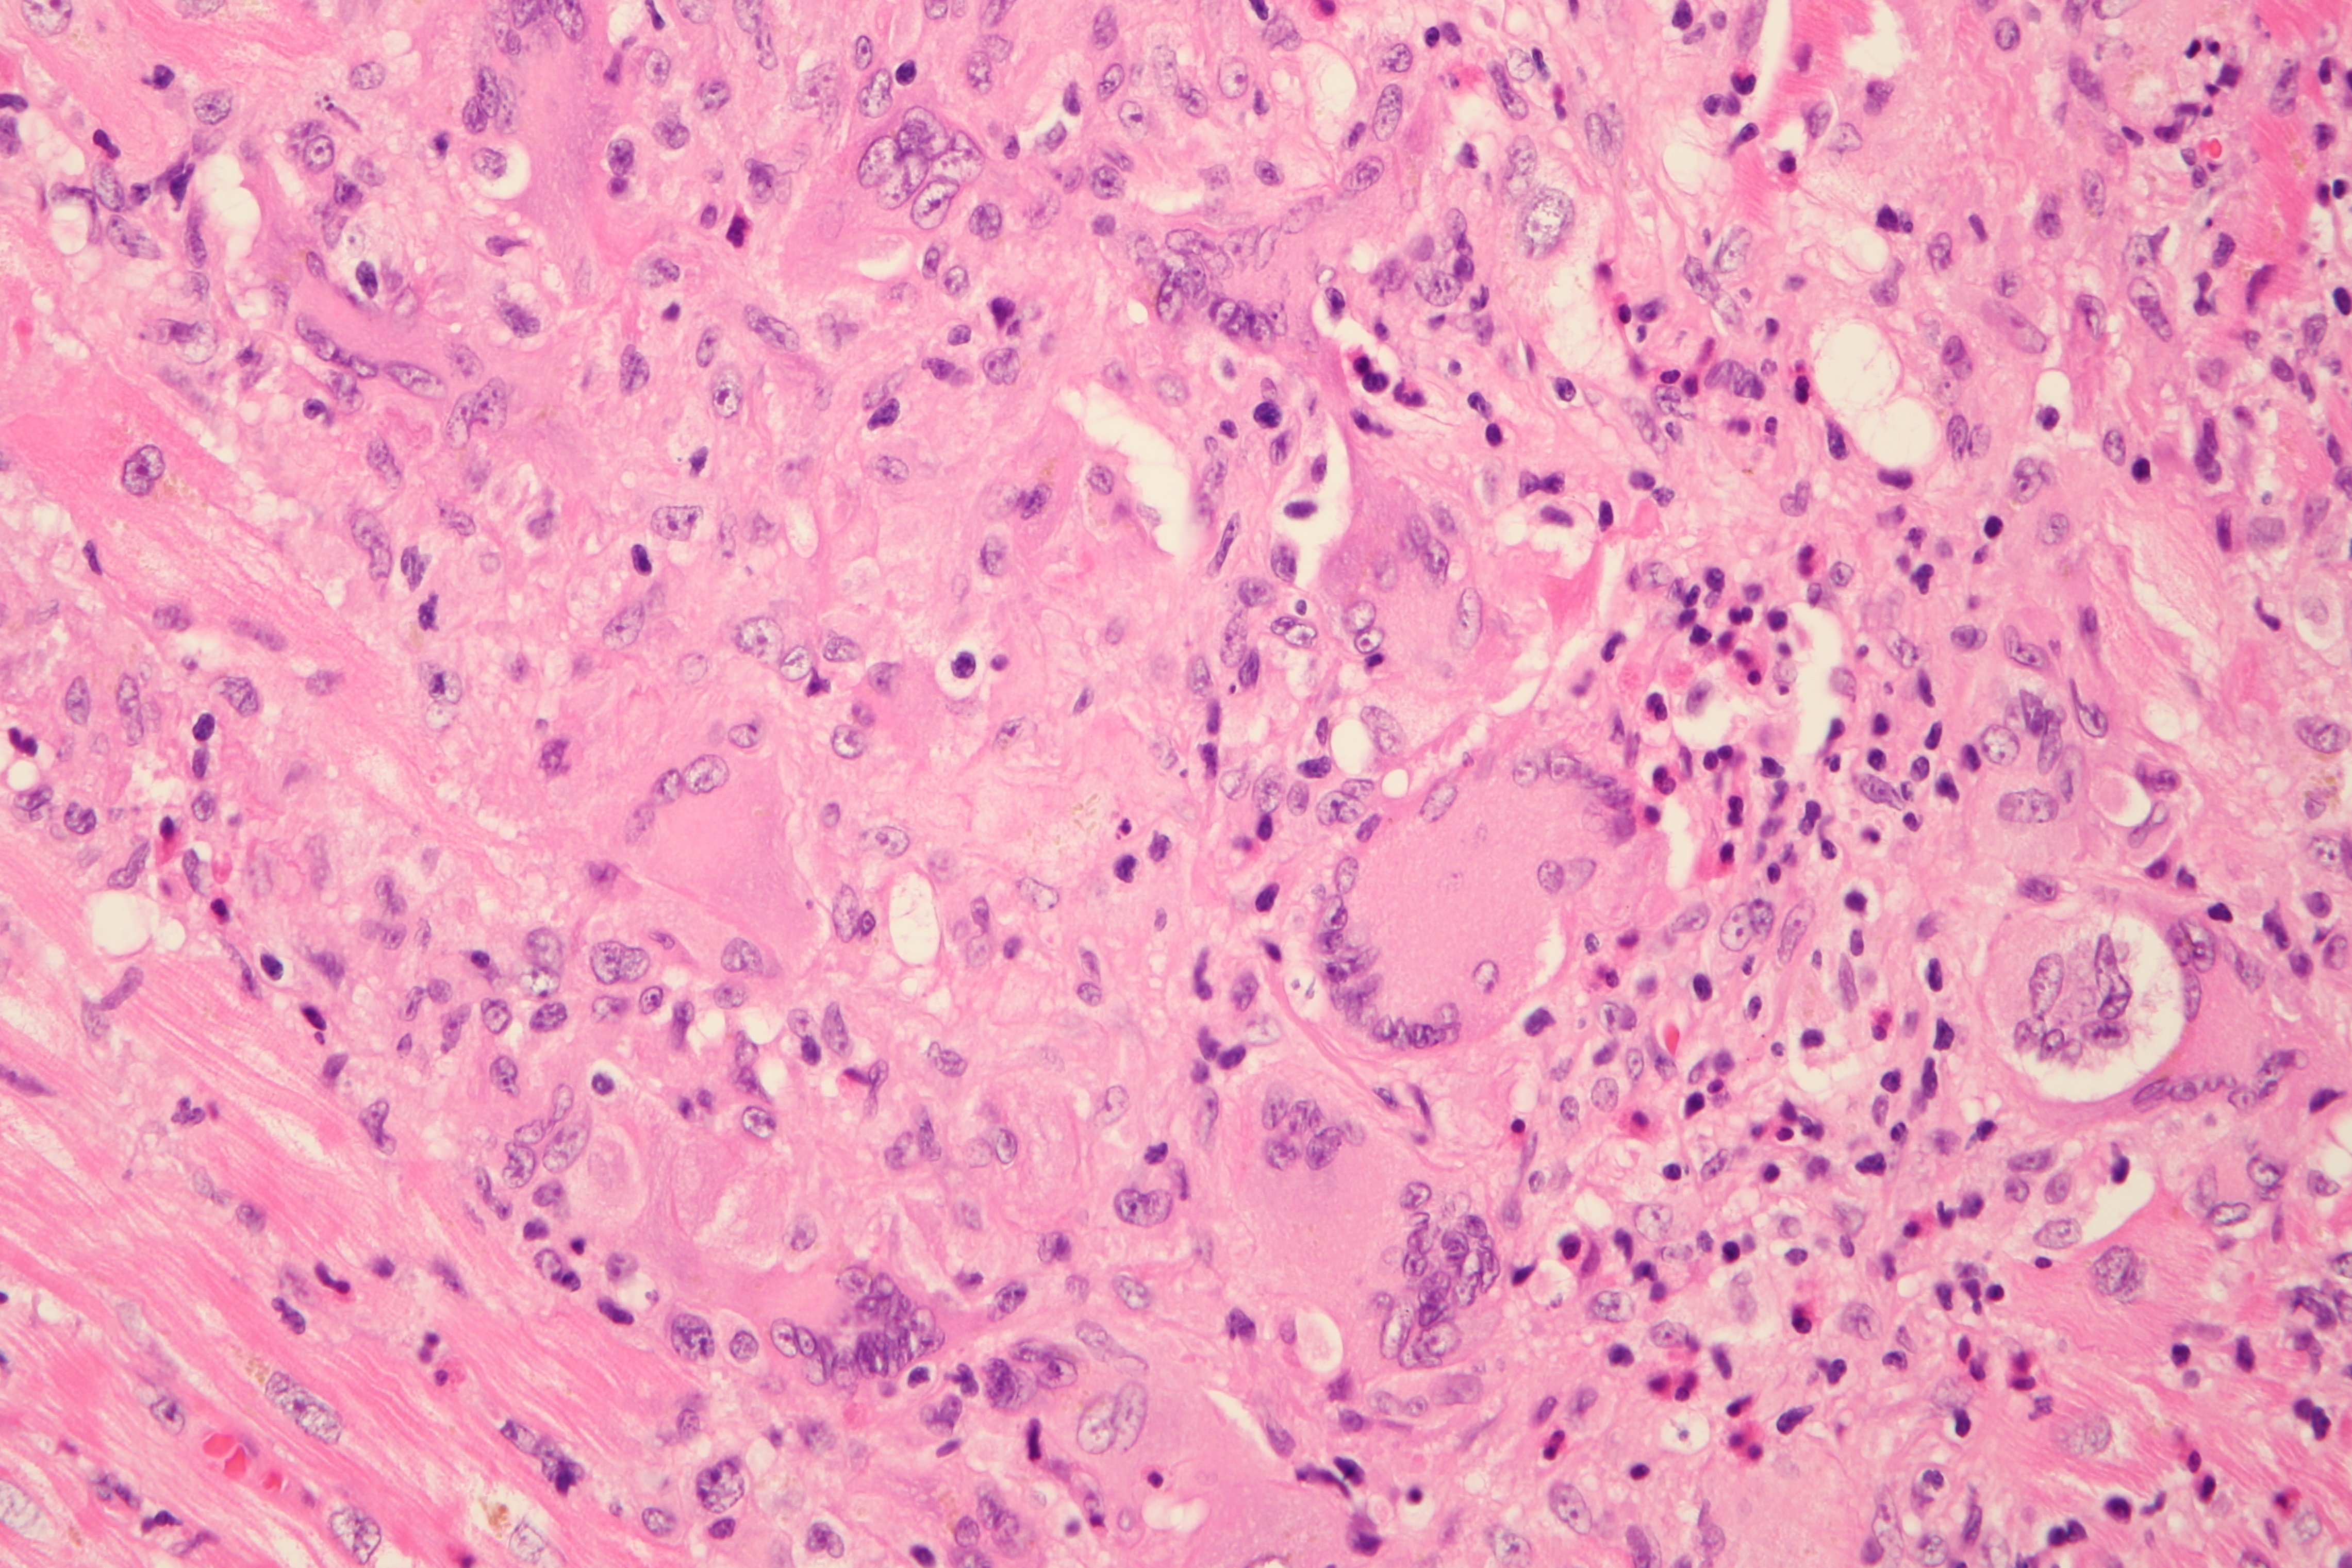

64-year-old woman with an unremarkable medical history presented with syncope while on holiday as a result of newly documented third-degree atrioventricular (AV) block.
Laboratory findings (on admission)
- high-sensitivity troponin T (1086 ng/L [normal range, 0-14 ng/L)
- brain natriuretic peptide (2164 ng/L [normal range, 10-155 ng/L])
ECG on admission revealed a complete AV block, junctional rhythm. ECG Holter monitoring reported pauses up to 5 seconds.
Figure 1 ECG od admission

Echocardiography on admission showed a borderline left ventricular (LV) ejection fraction (50-55%). Coronary angiography showed no pathologic features.
Video 1 TTE on admission
.gif)
Day 2 - Temporary pacing had to be instituted, and an endomyocardial biopsy was performed at the same time.
Figure 2 ECG with ventricular pacing spikes

Day 4 - Transthoracic echocardiography documented progression of LV systolic dysfunction (EF 30-35%). On the same day, a permanent dual-chamber pacemaker was implanted.
Video 2 Severe dysfunction of LV on TTE

Figure 3 Chest X-ray with pacing leads in right atrium and ventricle

Further progression of LV systolic dysfunction requiring levosimendan administration was observed within the next 2 days and the patient was indicated to endomyocardial biopsy (EMB).
Figure 4 The endomyocardial biopsy specimen revealed diffuse inflammatory cellulization with extensive tissue destruction and the presence of giant multinuclear cells.


Combined immunosuppressive therapy was considered. However, because of the development of nosocomial sepsis of unknown origin (C-reactive protein, 231 mg/L [normal range, 0-5 mg/L]; procalcitonin, 2.56 μg/L [normal range, 0-0.5 μg/L]) only 60 mg of prednisone was initiated.
However, further progression of low cardiac output with incessant ventricular tachycardia required acute implantation of a left ventricular assist device (LVAD) (Levitronix CentriMag, Waltham, MA) on the eighth day after admission (Figure 5).
Figure 5 LVAD Levitronix CentriMag

Because no recovery was observed, a long-term LVAD (Heart Mate II, Thoratec, Pleasanton, CA) was implanted on the 17th day after admission as a bridge to transplantation (Figure 6).
Figure 6 Heartmate II on a CT image

Five weeks after LVAD implantation, an electrical storm was triggered by pleomorphic ventricular arrhythmias, which became resistant to antiarrhythmic therapy with amiodarone.
Figure 7 Pleomorphic ventricular arrhythmias


Therefore, on the 60th day after admission, radiofrequency catheter ablation was performed using the transseptal approach. Substantial substrate modification was performed by applying lesions along the septum and around the mitral annulus. Catheter ablation was successful in preventing recurrences of ventricular arrhythmias.
Video 3 Radiofrequency ablation
.gif)
Subsequently, the patient was listed as an urgent candidate for heart transplantation. However, the clinical course was complicated by the development of severe aortic regurgitation, which was not present at the time of LVAD implantation.
Video 4 Severe aortic regurgitation seen on TTE
.gif)
Transcatheter aortic valve implantation was performed on the 138th day after admission using the transfemoral approach (EvolutR, 23 mm; Medtronic, Minneapolis, MN).
Video 5 TAVI procedure
.gif)
Six months after the initial presentation of fulminant myocarditis, the patient underwent orthotopic bicaval heart transplantation.
Figure 8 Heart transplant

A total of 7 endomyocardial biopsy procedures were performed postoperatively; none of them showed any signs of rejection or recurrence of giant cell myocarditis. Two months later, after recovery from a complicated postoperative course, the patient was repatriated to her country of origin in stable condition.
Clinical context
Idiopathic giant cell myocarditis (GCM) is a rare and frequently fatal type of myocarditis. In contrast to the variable clinical course of DCM due to lymphocytic myocarditis, the clinical course in GCM is usually characterized by acute or fulminant deterioration in left ventricular systolic function despite standard HF treatment, frequent ventricular arrhythmias, and heart block.
Using a broad spectrum of therapeutic approaches (pacemaker, LVAD Levitronix, LVAD Heart Mate II, RF catheter ablation, TAVI), the patient successfully underwent heart transplant.
Figure 9 A Complex Heart Team's Approach to a Patient With Giant Cell Myocarditis

Learning points
1) A triple immunosuppressive regimen may not always be appropriate in patients with GCM (infection, VAD).
2) RF ablation of VTs may be a life-saving procedure in patients with VAD
What are the triggers of VT after LVAD implantation?
3) What are the technical difficulties of RF ablation?
4) Aortic regurgitation caused by VAD implantation can be successfully treated by TAVI.
5) Heart transplant list is open to all patients in need, irrespective of their nationality.
References
Authors: Michal Pazdernik, Ivan Netuka, Jiri Maly, Jiri Kettner, Ludek Voska, Hynek Riha, Jan Pirk, Vojtech Melenovsky, Josef Kautzner.